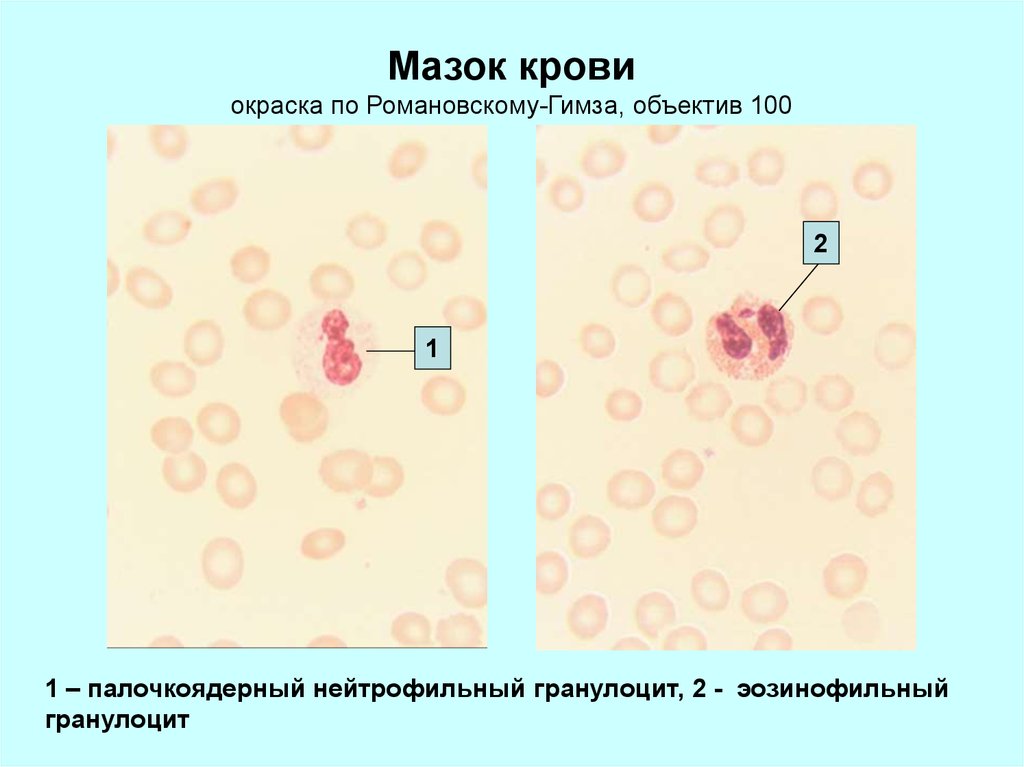

Similar presentations:
Кровь. Состав крови
1.
Кровь2.
Мазок кровиокраска по Романовскому-Гимза, объектив 40
1
2
1 - моноцит
2 – нейтрофильный гранулоцит
3.
Мазок кровиокраска по Романовскому-Гимза, объектив 100
2
1
1 – нейтрофильный гранулоцит, 2 – тромбоциты
1
4.
Мазок кровиокраска по Романовскому-Гимза, объектив 100
1
2
1 – моноцит, 2 – базоофильный гранулоцит
5.
Мазок кровиокраска по Романовскому-Гимза, объектив 100
2
1
1 – лимфоцит, 2 – нейтрофильный гранулоцит
6.
Мазок кровиокраска по Романовскому-Гимза, объектив 100
2
1
1 – палочкоядерный нейтрофильный гранулоцит, 2 - эозинофильный
гранулоцит
7.
Мазок кровиокраска по Романовскому-Гимза, объектив 100
1
1 – эозинофильный гранулоцит
8.
аЛимфоциты.
б
Сканирующая электронная микрофотография. Увеличение 18 000
(а) и 16 000 (б). На основании количества микроворсинок на доступной наблюдению
сферической поверхности клетки (1/2 всей ее поверхности) лимфоциты разделяют
на 3 группы: микроворсинчатые (а), умеренно микроворсинчатые (б) и сглаженные
(Волкова О.В. и соавт. Атлас сканирующей электронной микроскопии клеток, тканей
и органов, 1987).
9. Руководство по выполнению заданий
1. Поместите указатель мыши над кнопкой «Тест» и щелкнителевой клавишей мыши у Вас появится следующее окно.
2. В появившемся окне нажмите на кнопку «Выбрать».
3. После этого у Вас запуститься тестовая программа.
Отвечайте на вопросы.
Тест пройден?
Если Вы получили
неудовлетворительную
оценку
щелкните по этой кнопке
Если Вы получили
пароль
щелкните по этой кнопке
Возврат к началу
К оглавлению
Тест

biology
biology








